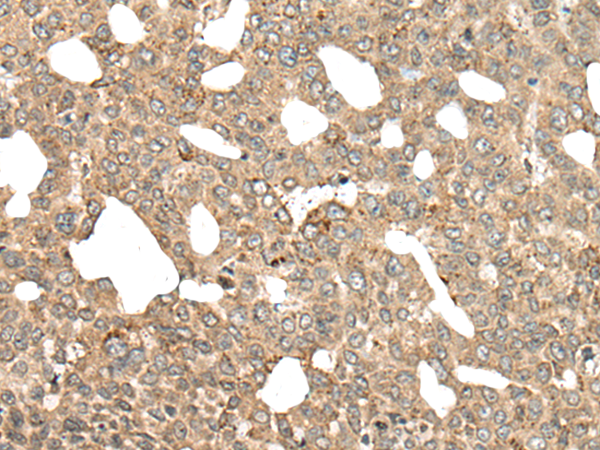

中文名稱(chēng):兔抗APC多克隆抗體
|
Background: |
This gene encodes a tumor suppressor protein that acts as an antagonist of the Wnt signaling pathway. It is also involved in other processes including cell migration and adhesion, transcriptional activation, and apoptosis. Defects in this gene cause familial adenomatous polyposis (FAP), an autosomal dominant pre-malignant disease that usually progresses to malignancy. Disease-associated mutations tend to be clustered in a small region designated the mutation cluster region (MCR) and result in a truncated protein product. |
|
Applications: |
ELISA, IHC |
|
Name of antibody: |
APC |
|
Immunogen: |
Synthetic peptide of human APC |
|
Full name: |
WNT signaling pathway regulator |
|
Synonyms: |
GS; DP2; DP3; BTPS2; DP2.5; PPP1R46 |
|
SwissProt: |
P25054 |
|
ELISA Recommended dilution: |
5000-10000 |
|
IHC positive control: |
Human liver cancer and human thyroid cancer |
|
IHC Recommend dilution: |
40-200 |

購(gòu)物車(chē)
購(gòu)物車(chē) 幫助
幫助
 021-54845833/15800441009
021-54845833/15800441009
